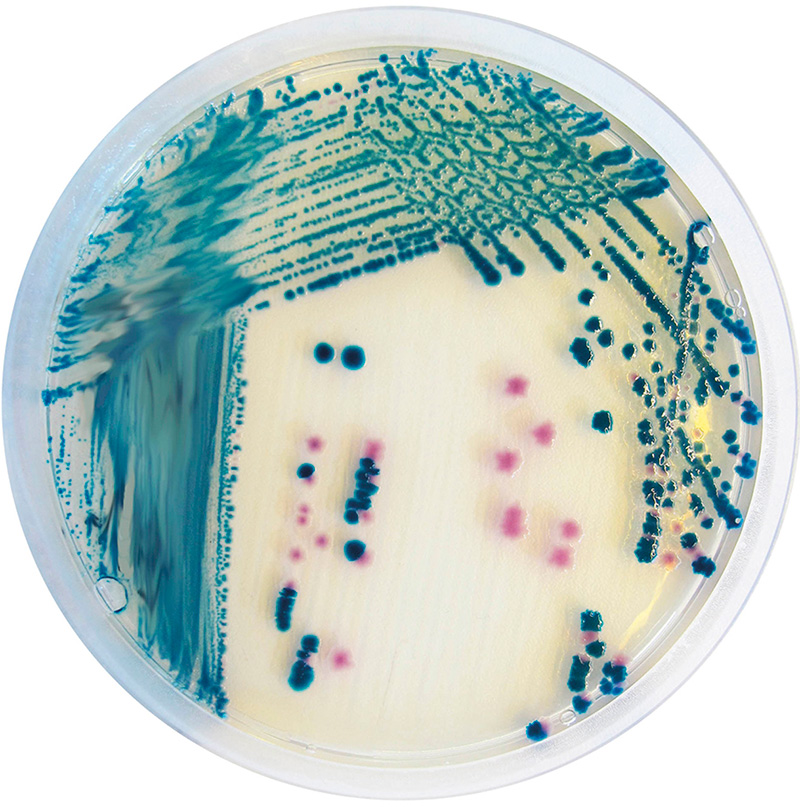

Yersinia enterocolitica: изображения бактерии и её среды















































/corenybacterium-pseudoTB_100x-equine-shoulder-mass-61.jpg)

:format(jpg)/f.elconfidencial.com%2Foriginal%2Fe3d%2Fd03%2F7ad%2Fe3dd037ad00c547ec1f73f9c5ed6923c.jpg)


























Раздел: Другие животные